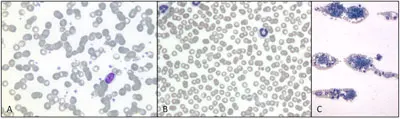
Featured Image

Current Thoughts on Coagulopathy Testing

Acquired bleeding disorders are fairly common in small animals, and inherited bleeding disorders are also known to occur.
Several methods of assessing hemostasis in dogs and cats exist. Patients that might benefit clinically from coagulation testing include those that present with signs of bleeding (especially bleeding from multiple sites); those bleeding with no history of trauma; or those with unexpected, excessive bleeding during a minor procedure (eg, dental cleaning) or routine surgery (eg, neuter).
Coagulation testing may also be indicated before invasive procedures in any animal that is suspected of having an increased risk for bleeding because of an underlying disease (eg, before liver biopsy in a patient with evidence of hepatic dysfunction) or in those with suspected exposure to drugs or toxins that may affect hemostatic function.
Physiology
Hemostasis has been traditionally considered to consist of 2 processes that occur sequentially:
Primary hemostasis involves platelet activation and formation of a platelet plug at the site of vascular endothelial injury. This fragile platelet plug serves as the initial barrier to bleeding.
Secondary hemostasis involves subsequent activation of the enzymes of the clotting cascade and results in the production of insoluble fibrin. This strengthens the initial platelet plug and provides an additional barrier to continued hemorrhage. The clotting cascade is further divided into the intrinsic pathway (consisting of factors XII, XI, IX, and VIII) and the extrinsic pathway (consisting of tissue factor and factor VII), both of which activate the common pathway (factors X, V, II, and I) (Figure 1).

Secondary hemostasis, with factors evaluated by screening coagulation tests. Reprinted with permission from Small Animal Critical Care. Silverstein D, Hopper K—St. Louis: Elsevier Saunders, 2008.
The clinical features of bleeding associated with defects in primary or secondary hemostasis differ (Box) and hence can be used to guide initial selection of coagulation tests. These tests can subsequently confirm the presence and severity of a clotting defect, in addition to the nature of the disorder. Because a platelet disorder is typically treated very differently from a clotting factor disorder, coagulation testing is of utmost importance during the management of bleeding animals.
Primary Hemostasis
Petechiation & ecchymoses
Bleeding at mucosal surfaces (epistaxis, melena, hematemesis, hematuria); pulmonary & ocular hemorrhage common
Multisite bleeding
Prolonged & repeated bleeding from wounds
Secondary Hemostasis
Hematoma formation
Bleeding into cavities (hemoperitoneum, hemothorax, hemopericardium, hemarthrosis) common
Bleeding often localized
Bleeding often delayed in onset
Considerations
Coagulation tests should be performed and their results interpreted carefully, together with the clinical findings of the patient. Ideally, blood samples should be collected via atraumatic venipuncture before the administration of any treatment. Proper sample handling techniques should be strictly followed. The jugular vein should not be used for venipuncture in patients suspected of having a coagulopathy because of its large size and possible difficulty in applying adequate pressure to stop bleeding. Following are common screening tests performed in an emergency setting to investigate a suspected coagulopathy.
Primary Hemostatic Coagulation Testing
Platelet Count
Purpose. Quantitative platelet disorders are detected via a platelet count. It should be performed in all patients suspected of having a coagulopathy.
Method. Platelet count is best assessed from a blood smear obtained by using anticoagulated blood collected via rapid, clean venipuncture. Since automated platelet counts may produce erroneous results, especially in cats, a manual blood smear analysis should also be performed.
Results. A normal platelet count of 160 to 400 × 109 cells/L will correspond with approximately 8 to 15 platelets per high-power (×100) field. Spontaneous hemorrhage is unlikely to occur unless the platelet count is below 30 to 50 × 109 cells/L (about 2–3 platelets per high-power field). However, excessive bleeding may occur in patients with higher platelet counts if surgical intervention is necessary, if the patient has dysfunctional platelets, or if secondary hemostasis is also deranged. The feathered edge and cell monolayer should also be thoroughly evaluated for the presence of any platelet clumps. Although the presence of platelet clumps often prevents an accurate platelet count, spontaneous hemorrhage due to thrombocytopenia is less likely to occur if many large clumps of platelets are observed (Figure 2).
Blood smear evaluation of a blood film from a dog (Wright’s Giemsa stain): Normal platelet density, magnification 100× (A); decreased platelet density, magnification 100× (B); platelet clumps surrounded by red and white blood cells at the feathered edge, magnification 10× (C).
Buccal Mucosal Bleeding Time
Purpose. The buccal mucosal bleeding time (BMBT) is a test of platelet function. It is indicated in patients suspected of having a primary hemostatic defect despite adequate platelet numbers. Its use and accuracy for the assessment of platelet function are controversial, but it is still widely used in clinical practice for lack of a more accurate or specific test.
Method. For a BMBT, the patient is restrained in lateral recumbency and may require light sedation. A strip of gauze is tied around the maxilla to fold up the upper lip sufficiently to cause moderate mucosal engorgement. It is important not to place the gauze too tightly so that blood vessels are not constricted. The BMBT should be performed with a commercial spring-loaded device that creates a small incision of uniform width and depth into the inside of the upper lip. An area devoid of visible blood vessels should be chosen. Any shed blood must be carefully blotted with filter paper, with extreme care taken not to blot the incision itself; doing so may disturb the fragile primary platelet plug (Figure 3). The time taken from incision to cessation of bleeding by first clot formation is recorded (normal = 2–4 minutes in dogs, 1–2.5 minutes in cats).

Buccal mucosal bleeding time evaluation in a dog. Filter paper is being used to carefully remove shed blood without touching the 2 incisions until the time of primary clot formation. Courtesy of Penn Animal Blood Bank, University of Pennsylvania School of Veterinary Medicine
Results. The BMBT is significantly prolonged in patients with a functional disorder of primary hemostasis (thrombopathia). Type I von Willebrand’s disease is one of the most common causes of thrombopathia in small animal patients and can be definitively diagnosed by factor quantification. There are many other causes of thrombopathia, including drug-induced thrombopathia (eg, aspirin), uremia, hepatopathy, and breed-specific disorders (for which specific diagnostic tests are frequently available). The BMBT will be substantially prolonged in patients with moderate to severe thrombocytopenia (platelet count < 80 × 109 cells/L) and should not be performed in these patients.
Although rarely performed, additional tests of primary hemostasis are available, including clot retraction, antiplatelet antibody, platelet adhesion, and platelet aggregation testing.
Secondary Hemostatic Coagulopathy Testing
Prothrombin Time
Purpose. The prothrombin time (PT), also known as one-stage PT, is the principal test of the extrinsic pathway, but it also tests the common pathway. Because of the short half-life of factor VII, PT is a very sensitive test for early vitamin K deficiency or antagonism (eg, anticoagulant rodenticides). This test result is not affected by the presence of primary hemostatic disorders.
Results. For this measurement to be prolonged, extrinsic factor activity must be below 25% to 30% of normal levels. With use of citrated whole blood, the reported sensitivity and specificity are 85.7% and 95.5%, respectively, meaning that some defects of the extrinsic pathway will not be detected with this method and that falsely prolonged results may occur. Generally, prolongations beyond 20% of normal are likely to be clinically significant and warrant further investigation, whereas mild prolongations should be interpreted with caution.
Activated Partial Thromboplastin Time
Purpose. The activated partial thromboplastin time (aPTT) tests the intrinsic and common pathways. It is typically prolonged in patients with heritable factor deficiencies (eg, hemophilia A) or hepatic synthetic dysfunction, or in patients with disseminated intravascular coagulation that have consumed clotting factors.
Results. Depletion of at least 1 factor from the extrinsic clotting pathway to below 25% to 30% of normal concentration is necessary for prolongation of the aPTT. This test is not affected by the presence of primary hemostatic disorders. With use of citrated whole blood, the sensitivity has been reported as high as 100% and the specificity as approximately 83%. Generally, prolongations beyond 20% of normal are likely to be clinically significant, whereas mild prolongations should be interpreted with caution.
Most clinical laboratories can measure the PT, aPTT, and ACT, although special sample handling and shipment are often required.
Point-of-care analyzers can also provide rapid and reliable means of evaluating secondary hemostasis in the emergency setting. Abnormal results that do not correlate with clinical findings should be verified by conventional laboratory testing.
Activated Clotting Time
Purpose. The activated clotting time (ACT) is a simple screening test of the intrinsic and common pathways, although hypofibrinogenemia, severe defects in primary hemostasis (platelet count < 10 ¥ 109 cells/L), or the extrinsic pathway may also lead to prolongations.
Method. To perform this test, whole blood is collected by rapid, clean venipuncture. The first few drops of blood are discarded to eliminate any tissue factor, and the needle is changed. The remaining blood is added to glass tubing that contains (diatomaceous) Fuller’s earth. The tube is then incubated at a temperature of 99° F (37° C) and inverted every 10 seconds until visible clot formation occurs.
Results. Normal values are 60 to 100 seconds in the dog and 50 to 75 seconds in the cat. The ACT is not usually prolonged until a measured clotting factor is depleted below 10% of normal or multiple factors are significantly decreased. It is, therefore, a relatively insensitive test compared with the aPTT but is easy to perform.
Significant bleeding of any cause is likely to lead to prolongations of PT, aPTT, and ACT and to consumption or loss of platelets, which will result in some degree of thrombocytopenia. These alterations are usually mild; a substantial change of one measure may still localize a primary problem (Table).
Additional Tests for Secondary Hemostatic Disorders
A rodenticide screening panel can be performed to verify the presence of such toxins when indicated. In addition, clotting factor analysis can be performed on samples collected before the administration of any blood products in animals suspected of having a heritable factor deficiency (ie, hemophilia).
Tests of Fibrinolysis
Fibrin Degradation Products
Purpose. Fibrin degradation products (FDPs) are generated from degradation of fibrinogen or fibrin, in both its soluble and cross-linked insoluble forms.
Results. Elevated FDP may be an indicator of increased fibrinolysis, as in disseminated intravascular coagulation, or blood clot formation. FDPs may also be elevated in liver disease because of decreased clearance or in many inflammatory states because of associated dysfibrinogenemia.
d-DimersPurpose. d-dimers are degradation products of insoluble cross-linked fibrin. As such they are more specific than FDPs as an indicator of blood clot formation and subsequent fibrinolysis.
Results. d-dimers are elevated in disseminated intravascular coagulation or recent thrombus formation; increased levels are also seen in other disease processes, including neoplasia. Elevations in d-dimer concentrations are considered sensitive but nonspecific for the detection of such hemostatic abnormalities.
Table: Common Causes of Bleeding & Major Hemostatic Test Findings
D = decreased; N = normal; P = prolonged
Future Advancements in Testing
Current thoughts on the physiology of coagulation have changed with the development of the cell-based model of coagulation. The different components of the clotting process are now known to occur simultaneously on the endothelial cell surface. The differing clinical signs seen with defects in the traditional primary and secondary pathways, however, are still very useful in choosing appropriate clinical tests in the diagnostic work-up of the bleeding patient.
Additional diagnostic tests are likely to become more widely available in the future as more is discovered about the coagulation process and further technologies become validated. Thromboelastography (TEG) is a newer method for global assessment of coagulation (Figure 4). However, TEG cannot identify the underlying cause of a coagulopathy as precisely as does the conventional testing described earlier. This may change in the future as additional research is performed. In addition, TEG and interpretation of the thromboelastogram allow identification of a hypercoagulable state, an area of growing interest in critical care medicine.

Thromboelastographic tracing from a hypocoagulable patient (A) and a hypercoagulable patient (B). Thromboelastography allows rapid visual identification of a patient’s coagulation status by showing a tracing of clot strength against time. Tracing A indicates slower clot formation, and the final clot is weaker (narrower tracing) than in B (wider tracing).
Critical Points
Coagulation can be broken down into primary and secondary hemostasis.
Appropriate differentiation of problems in these areas, based on clinical signs, can help prioritize appropriate testing and differential diagnoses.
Many different causes of coagulopathy exist, but the most common can be easily differentiated by using readily available testing.
As our understanding of coagulation progresses, the range of tests available is likely to expand, but the most commonly used tests remain useful for identification of frequently encountered problems.